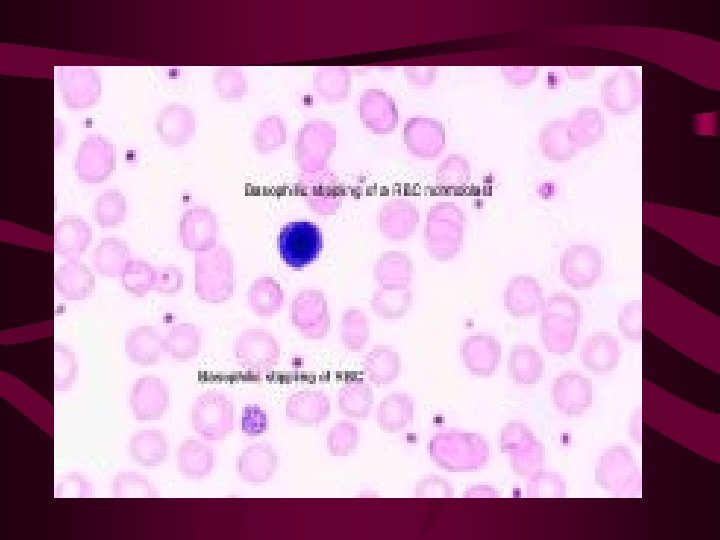

3 OPOJNI PLINOVI ANESTETICI NARKOTICI 3 a ALKOHOLI

- Slides: 51
3. OPOJNI PLINOVI ANESTETICI / NARKOTICI
3 a. ALKOHOLI • • 3 mehanizma toksičnog djelovanja: 1. iritacija 2. opći narkotički učinak 3. metaboličko djelovanje
Abuse during pregnancy can cause Fetal Alcohol Syndrome Skin folds at the corner of the eye Low nasal bridge Short nose Indistinct philtrum (groove between nose and upper lip) Small head circumference Small eye opening Small midface Thin upper lip
Metilni alkohol • 1. i 2. učinak slabog intenziteta i bez posebnih karakteristika • 3. vrsta učinka je najopasnija oduzima vodik enzimu alkohol-dehidrogenazi (ADH) • nastanak formaldehida, a potom i mravlje kiseline
POSLJEDICA • ova 2 metabolita stimuliraju u organizmu stvaranje metaboličkih kiselina • METABOLIČKA ACIDOZA (alkalna rezerva pada na oko 10 -15 vol%)
Klinički tijek: • 1. period latencije od 6 do 10 sati (dođe li u toj fazi do konzumacije etilnog alkohola, NEĆE se razviti slika trovanja, jer je to antidot) • 2. abdominalne kolike kao 1. simptom, slijede tahipnea, te izraziti očni simptomi, zbog djelovanja mravlje kiseline na čunjiće i štapiće u retini i na cerebralne jezgre diplopija, strabizam, midrijaza, sljepoća
TH: • !!!ETILNI ALKOHOL KAO ANTIDOT ( on okupira ADH i onemogućava metaboličko djelovanje metilnog alkohola) • ! bikarbonati sa svrhom alkalizacije •
Poznata trovanja metilnim alkoholom-u vrijeme prohibicije u SAD • 18. 12. 1917. USKongres izglasao prohibiciju. • 16. 1. 1919. Odluka ratificirana i dodana kao 18. Amandman američkog Ustava. • Ukinuta 5. 12. 1933.
Etilen-glikol ( antifriz) • Glikol = dvovaljani alkohol • Kad dođe u krv metabolizira se u oksalnu kiselinu, koja ima jaki afinitet za Ca hipokalcemija, depozicija Caoksalata u mozgu smrt kao da otrovani boluje od ekspanzivnog procesa • Th. etilni alkohol
• Etilen-glikol nije klasični profesionalni otrov, ali tioglikolna kiselina jest • (keratolitik koji se koristi za trajnu ondulaciju) profesionalna keratoliza kod frizerki
Glicerol • bezopasan trovaljani alkohol, ALI • kada gori, nastaje jaki iritans akrolein, koji je kod dugotrajnih ekspozicija i karcinogen (CA bronchi) • kada se esterificira (spoji s kiselinom), posebno s dušičnom kiselinom NITROGLICEROL
Djelovanje NITRITNI UČINAK!!! • Komponente: • 1. Angiotropno i bronhotropno djelovanje (dilatacija) • 2. Methemoglobinemija • Oksidacija hema methem • Oksidacija globina bazofilni • punkati (Heinzova tjelešca) • Oksidacija stromatina hemoliza
3. Hipotenzija, methemoglobinemična cijanoza (sivkasto-plava) • “Vaftohilari” (“ljudi obojenih usana”) populacija u Grčkoj sa kongenitalnom methemoglobinemijom, uslijed deficita enzima dialforaze. • Inače organizam od methemoglobinemije čuva glukoza-6 -fosfat-dehidrogenaza.
4. Simptomi hipoksemije i hipoksije • Th: redoks-sistemi (metilensko modrilo, ali je dobar i C-vitamin)
3 b. HALOGENIRANI UGLJIKOVODICI ALIFATSKOG REDA • B 1. ZASIĆENI • metil-klorid • =industrijski hladionički plin (NE kućni frižideri) • Potentan toksin • 1. AKUTNO DJELOVANJE • neznatni iritirajući učinak-nema znakova upozorenja, radnik radi dalje
• osrednji narkotički učinak (kao blaže pijanstvo), • simptomi sa strane oka (diplopija, strabizam, zamućenje vida, nistagmus brzog iscrpljenja- • Macewanov znak spontano sužavanje i širenje zjenice), • javljaju se i abdominalne kolike.
• Metabolički učinak se ne razvije do krajnje mjere, jer uslijedi prije smrt zbog paralize respiratornog centra • 2. KRONIČNO TROVANJE • Polineuropatije
Metilen-klorid • di-Cl-metan (otrovniji je “para” od “meta” oblika) • lagano iritirajuće, izrazito narkotičko i hepatotoksično metaboličko djelovanje • tri-Cl-metan ili kloroform • izraziti hepatotoksin i kardiotoksin
tetra-Cl-metan ili tetra-Cl-ugljik • slabi iritans, • slabi narkotik, • jako metaboličko djelovanje u smislu teške centrilobularne hepatocelularne nekroze, te tubularne bubrežne nekroze (anurija kao prvi znak)
Alcohol abuse causes Cirrhosis
• hemoragička dijateza • sinergizam sa etilnim alkoholom tahiaritmija i fibrilacija • Pare CCl 4 su teže od zraka otrovani je u težoj situaciji kad padne na tlo nego kad stoji • Th. NEMA SPECIFIČNOG ANTIDOTA, postoje preporuke da se daje Ca
metil-bromid • Nakon latencije od nekoliko sati • · djelovanje na CNS epileptički status (obrnuto nego kod anorganskih spojeva Br, koji su se upotrebljavali za sedaciju) • · djelovanje na bubreg anurija • · djelovanje na pluća plućni edem • NEMA UPOZORAVAJUĆIH IRITATIVNIH TEGOBA!
HALOGENACIJA S F OPASNIJA OD ONE SA Cl • F ima jaki afinitet za H 2 stvara se HF (fluorovodična kiselina), koja je jaki kombustiv i koroziv • di-fluoro-di-kloro-metan freon • = neotrovan plin koji se koristi u kućnim hladnjacima, kao potisni plin u sprayevima i sl.
B 2. NEZASIĆENI • Etilen • vrlo koristan plin, koji se dobiva iz nafte procesom krekovanja (razbijanja velikih molekula pod tlakom i pri povišenoj temperaturi) • Polimerizacijom nastaje polietilen tj. plastika
Halogenacijom- VCM (polimer PVC) • VCM izaziva: • 1. sklerodermiji slične promjene, Raynaud sy • 2. akroosteolizu batičasti prsti
• 3. angiosarkom jetre • ( hemangioendoteliom; proliferira endotel) epoksidacija VCM-a u jetri epoksidi su karcinogeni • 4. primarna fibroza jetre portalna hipertenzija splenomegalija, pancitopenija
• sumporougljik • neurotoksin (encefalopatije), kardiotoksin
3 c. AROMATSKI UGLJIKOVODICI • benzen • Organska kemija je kemija benzenove cikličke strukture , bruto formula C 6 H 6. • Za razliku od lančanih struktura, gdje toksičnost RASTE supstitucijom, u slučaju benzena ona PADA!!!
Tijek trovanja: • u početku lagana euforija, psihomotorni nemir • gubitak kritičnosti nesvijest koma • On je i antimitotik, posebice napada koštanu srž pancitopenija, leukemije • Pretpostavlja se i hepatotoksični učinak
• Organizam nastoji eliminirati benzen oksidacijom u fenol u urinu često negativan nalaz na C-vitamin, a pozitivan na fenol
Nitroderivati benzena • mono-nitro-benzen ( tzv. “ulje od mirbana”) • miris po gorkim bademima • patogeneza se osniva na nitritnom učinku • meta-di-nitro-benzen • patogeneza se osniva na nitritnom učinku, ali i hepatotoksičnosti i neurotoksičnosti (ekscitacijski učinak)
mono-amino-benzen ( anilin) • • Otrov, dok ANILINSKE BOJE TO NISU Klinički: abdominalne kolike stezanje u prsima nemir hipotonija glavobolja
• U organizmu se oksidira • prvi oksidacijski produkt otrovniji od samog anilina i zove se • para-amino-fenol • para-amino-benzen • “Ursol” za bojanje životinjskog krzna, boja za kosu
• Formulacija sa 2 NH 2 skupine u parapoložaju alergogeno djelovanje!!! (eritem, ekcem, alopecija areata, glavobolje)